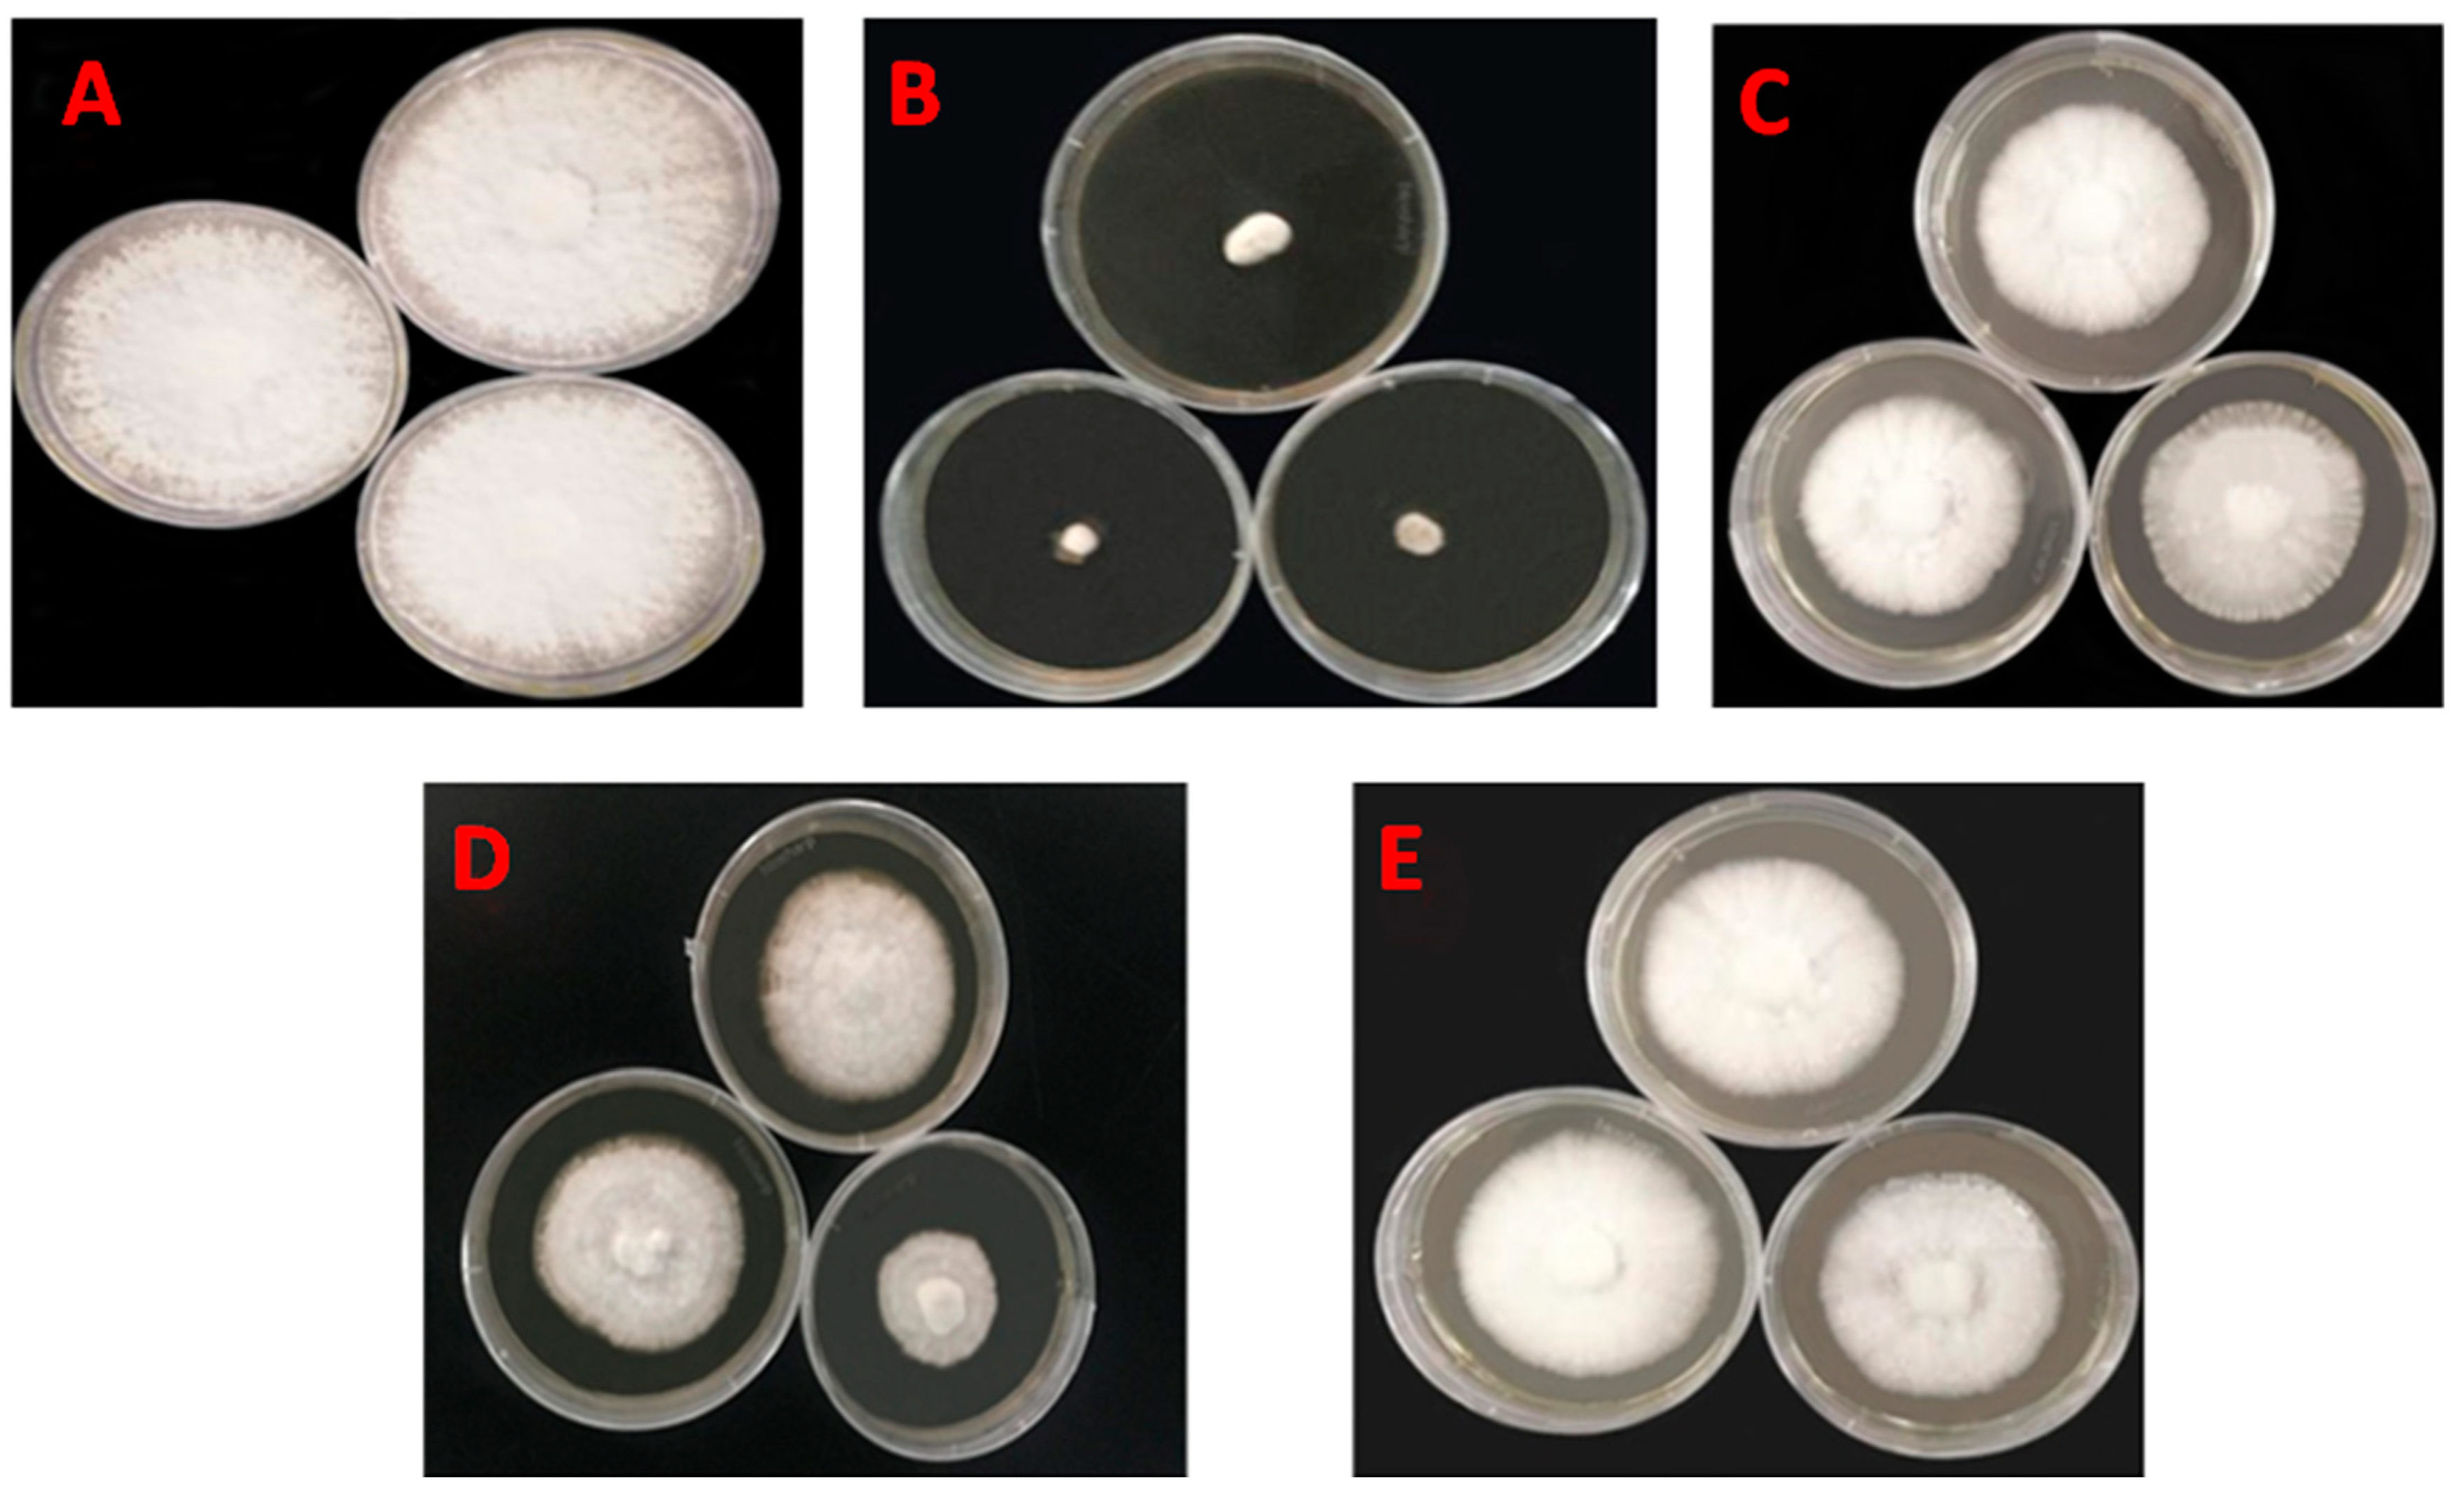
Horticulturae 11 00471 g002

Distribution of Oligaphorura ursi in Morchella Cultivation Soil, Screening of Pesticides, and Analysis of Their Effects on Mycelial Growth and Pesticide Residues
Abstract
:1. Introduction
2. Materials and Methods
2.1. Experimental Materials
2.2. Experimental Methods
2.2.1. Hazard Investigation of O. ursi
2.2.2. Spatial Distribution Pattern of O. ursi in Soil
2.2.3. Screening of Insecticides for Control of O. ursi
2.2.4. Effect of Pesticides on Mycelium Growth of Morchella
2.2.5. Detection of Pesticide Residues
2.3. Data Analysis
3. Results
3.1. Investigation of O. ursi Hazard and Determination of Distribution Type
3.1.1. Investigation of O. ursi Populations in Morchella Cultivation Soil
3.1.2. Spatial Distribution Pattern of O. ursi in Morchella Cultivation Soil
3.2. Laboratory Screening of Insecticides
3.3. Screening of Field Insecticides for O. ursi
3.4. Effects of Pesticides on Mycelial Growth of Morchella
3.5. Pesticide Residue Detection Method
4. Discussion
Author Contributions
Funding
Data Availability Statement
Conflicts of Interest
References
- Kong, L.; Zhang, L.; Hu, W.H.; Zhu, L.Y.; Wang, H.L.; Li, Y.J.; Jia, Y.S. The Chinese edible fungi industry-current status and future predictions. Acta Edulis Fungi 2016, 23, 104–109. [Google Scholar] [CrossRef]
- Zipora, T.; Segula, M. True morels (Morchella)-nutritional and phytochemical composition, health benefits and flavor: A review. Crit. Rev. Food Sci. 2017, 58, 1888–1901. [Google Scholar] [CrossRef]
- Zhang, J.X.; Chen, Q.; Huang, C.Y.; Gao, W.; Qu, J.B. The development history, present situation and trend of edible mushroom industry. Fungi 2015, 34, 524–540. [Google Scholar] [CrossRef]
- Zhang, Y.M.; Li, X.B.; E, H.C.; Zhou, C.Y.; Zhao, X.Y. Status of Chinese edible fungi trade and comparative analysis of standards of edible fungi pesticide residue limits at home and abroad. China Agric. Univ. 2022, 27, 145–163. [Google Scholar] [CrossRef]
- Qiao, T.; Li, J.Z.; Dai, L. Research progress on classification and identification methods and artificial cultivation technology of morel mushrooms. Edible Fungi China 2022, 41, 6–11. [Google Scholar] [CrossRef]
- Tang, J.; Wang, Y.; Xu, Y.Y.; Tan, H.; He, X.L.; Yu, Y.; Chen, Y.; Peng, W.H. Research Progress on key issues of Morchella Industry Development. Fungus Res. 2021, 19, 217–231. [Google Scholar] [CrossRef]
- Wang, G.Z.; Ma, C.J.; Zhou, S.; Põldmaa, K.; Tamm, H.; Luo, Y.; Guo, M.P.; Ma, X.L.; Bian, Y.B.; Zhou, Y. First Report of Cobweb Disease of Auricularia polytricha Caused by Cladobotryum cubitense in Xuzhou, China. Plant Dis. 2018, 102, 1452. [Google Scholar] [CrossRef]
- Jia, S.B.; Li, Z.H.; Zhang, Y.P.; Zhao, Y.; Yue, L.R. The catalogue search of the new taxonomic system of jumpers. J. Liaocheng Univ. 2010, 23, 38–41. [Google Scholar] [CrossRef]
- Xie, Z.J. Biodiversity Pattern of Equinoctial Jumping and Its Community Construction Mechanism in the Vertical Natural Zone of Changbai Mountain; University of Chinese Academy of Sciences (Northeast Institute of Geography and Agroecology, Chinese Academy of Sciences): Jilin, China, 2022. [Google Scholar] [CrossRef]
- Chen, T. Soil Springtail Community Diversity and Its Patterns in Eastern China Agricultural Areas; Harbin Normal University: Harbin, China, 2022. [Google Scholar] [CrossRef]
- Liu, W.; Cai, Y.; He, P.; Ma, X.; Bian, Y. Occurrence Patterns and Control Measures of Pests and Diseases in Morel Cultivation. J. Edible Fungi 2019, 26, 3–5+128–134. [Google Scholar] [CrossRef]
- Zhu, F.C. Occurrence rule and comprehensive control technology of edible fungus springtail pests. Edible Fungi 2017, 39, 71–72. [Google Scholar] [CrossRef]
- Dong, X.Y.; Jing, J.G. Screening test of peanut underground pest pesticides. Bull. Agric. Sci. Tech. 2021, 173–175. [Google Scholar] [CrossRef]
- Lin, J.S.; Luo, X.; Qu, S.X.; Jiang, N.; Hou, L.J.; Li, H.P.; Ma, L. Identification of springtail pests on Morchella and insecticides selection. Plant Prot. 2020, 46, 174–180. [Google Scholar] [CrossRef]
- Liu, Q.; Dong, J.C.; Cheng, W.Z.; Bai, R.X.; Shen, K.; Jiang, Z.L. Field control efficacies of eight pesticides to Tetranychus cinnabarinus and Hypogastrura communis on Bletilla striata. Plant Protect. 2020, 46, 276–280+286. [Google Scholar] [CrossRef]
- Yang, H.; Zhao, Z.H.; Wang, R.X.; Dong, M.F.; Song, W.G. Safety and risk assessment of pesticide residues in edible fungi. Acta Edulis Fungi 2011, 18, 105–110. [Google Scholar] [CrossRef]
- Liu, H. Study on Cultivation Techniques of Three Edible Fungi in Guizhou. Master’s Thesis, Guizhou University, Guiyang, China, 2021. [Google Scholar] [CrossRef]
- Zhou, H.B.; Chen, L.; Chen, J.L.; Cheng, D.F.; Liu, Y.; Sun, J.R. Effect of intercropping between wheat and pea on spatial distribution of Sitobion avenae based on GIS. Sci. Agric. Sin. 2009, 42, 3904–3913. [Google Scholar] [CrossRef]
- Wang, W.; Zhang, R.F.; Liu, H.Y.; Zhang, Y.; Yao, J. Spatial distribution pattern of common meadow bug Lygus pratensis (Linnaeus) in Xinjiang cotton fields. Plant Prot. 2016, 43, 972–978. [Google Scholar] [CrossRef]
- Yan, H.J.; Liu, X.J. Advances in ecotoxicology of pesticides on soil springtail pests. Jiangsu Agric. Sci. 2012, 40, 6–9+92. [Google Scholar] [CrossRef]
- Li, Y.P.; Sun, L.J.; Liu, Y.J.; Hu, Y.; Wu, J.X. Effects of eight insecticides on Scatopse sp. and their residue analysis in edible fungi. Plant Prot. 2009, 36, 261–267. [Google Scholar] [CrossRef]
- Zhao, H.Y.; Luo, L.; Zhang, Q. Research on pesticide multi-residue detection methods in vegetables and fruits. J. Food Saf. Qual. 2019, 10, 6343–6348. [Google Scholar] [CrossRef]
- LI, M.T.; Wang, N.; MAYLA Turdibek. Research progress on morel mushroom cultivation and selenium-rich control technology. Jiangsu Agric. Sci. 2021, 49, 20–27. [Google Scholar] [CrossRef]
- Ji, J.; Chen, X.; Lin, J.Z.; Zhang, Y.X. Functional responses of two predatory mites to Hypogastrura communis (Collembola: Hypogastruridae). Acta Edulis Fungi 2009, 16, 72–74. [Google Scholar] [CrossRef]
- Feng, X.J. Toxic Effects and Thresholds of Polycyclic Aromatic Hydrocarbons (PAHs) in Different Soils on the Folsomia candida; Nanjing University of Information Science & Technology: Nanjing, China, 2023. [Google Scholar] [CrossRef]
- Wu, M.X.; Wu, J.; Yang, Y. Study on the Diseases and Pests in Auricularia polytricha and their Control Techniques in Yuping County. Plant Dr. 2014, 27, 53–54. [Google Scholar] [CrossRef]
- Li, H.H. Composition of Arthropod Communities in Bletilla striata (Thunb.) with the Occurrence Pattern of Major Pests and Screening of Control Pesticides; Xinjiang Agricultural University: Xinjiang, China, 2024. [Google Scholar] [CrossRef]
- Liu, D.D. The Community Patterns of soil Oribatida and Collembola in the Vertical Zone of Changbai Mountain Vegetation; Northeast Forestry University: Harbin, China, 2024. [Google Scholar] [CrossRef]
- Wang, J.K.; Liang, J.; Xie, J.Y.; Fang, L.; Wang, H.R.; Wang, L.P. Control efficiency and application methods of four pesticides for taro rotten skin. Zhejiang Agric. Sci. 2021, 62, 978–980. [Google Scholar] [CrossRef]
- Hong, B. Toxicity Assessment of 19 Pesticides on Aino Verticillium and Their Effect on Edible Fungi Mycelial Growth; Guizhou University: Guiyang, China, 2023. [Google Scholar] [CrossRef]
- Zhao, X.N.; Luo, J.; Wu, M.X. Effect of imidacloprid on the prevention of mushroom phoridae and on the growth of edible mushroom mycelium. Edible Fungi China 2011, 30, 54–56. [Google Scholar] [CrossRef]
- Fan, Y.W. Study on Biochar-Blended Cultivation Substrate for Edible Fungus. Master’s Thesis, Shandong Agricultural University, Taian, China, 2021. [Google Scholar] [CrossRef]
- Song, W.G.; Yang, H.; Wang, W.M.; Qu, M.Q.; Zhang, X. Residue detection and safety of imidacloprid in edible fungi. Acta Edulis Fungi 2012, 19, 86–90. [Google Scholar] [CrossRef]
- Wu, Y.C.; Qi, C.Y.; Zhao, H.Q. Determination of 56 pesticide residues in shiitake mushrooms by QuEChERS-ultra performance liquid chromatography-tandem mass spectrometry. J. Pestic. Sci. 2018, 20, 58–66. [Google Scholar] [CrossRef]
- Shang, X.B.; Han, X.L.; Zhang, J.H. Investigation of edible mushroom pests and diseases and monitoring of pesticide residues in Guangdong Province. Hunan Agric. Sci. 2013, 28–29+35. [Google Scholar] [CrossRef]

| Pesticide | Dilution |
|---|---|
| 10% nitenpyram AS | 1000 |
| 4.5% beta-cypermethrin EC | 1600 |
| 3.5% lambda-cyhalothrin·emamectin benzoate ME | 3000 |
| 40% phoxim EC | 800 |
| 2.5% lambda-cyhalothrin EW | 600 |
| 8000 IU/mg Bacillus thuringiensis WP | 266 |
| 1.8% abamectin EC | 1600 |
| 50% thiamethoxam WDG | 4000 |
| 150 g/L indoxacarb EC | 4000 |
| 0.3% azadirachtin EC | 600 |
| Pesticide | Dilution |
|---|---|
| 10% nitenpyram AS | 500 |
| 2.5% lambda-cyhalothrin EW | 500 |
| 4.5% beta-cypermethrin EC | 800 |
| 0.3% azadirachtin EC | 300 |
| 1.8% abamectin EC | 800 |
| 40% phoxim EC | 400 |
| CK | — |
| Quadrat | Number of Collembola | Total Quantity | ||
|---|---|---|---|---|
| Site No. 1 | Site No. 2 | Site No. 3 | ||
| 1 | 7.60 ± 2.73 a | 5.60 ± 1.54 a | 9.20 ± 2.66 a | 5.42 ± 0.61 a |
| 2 | 4.00 ± 1.52 a | 10.60 ± 2.01 a | 7.60 ± 1.81 ab | 5.93 ± 0.59 a |
| 3 | 4.20 ±1.46 a | 5.20 ± 1.74 a | 2.60 ± 0.93 ab | 7.49 ± 0.75 a |
| 4 | 9.00 ± 2.85 a | 8.80 ± 2.42 a | 5.60 ± 1.36 ab | 6.04 ± 0.66 a |
| 5 | 9.00 ± 1.97 a | 6.60 ± 2.20 a | 6.80 ± 2.04 ab | 7.09 ± 0.71 a |
| 6 | 10.00 ± 2.43 a | 7.40 ± 1.57 a | 5.60 ± 2.01 ab | 7.67 ± 0.69 a |
| 7 | 10.00 ± 2.56 a | 8.60 ± 2.16 a | 5.40 ± 0.75 ab | 6.36 ± 0.73 a |
| 8 | 9.00 ± 2.00 a | 4.40 ± 2.56 a | 6.20 ± 2.22 ab | 5.80 ± 0.61 a |
| 9 | 3.40 ± 1.54 a | 4.20 ± 1.36 a | 6.00 ± 1.48 b | 7.67 ± 0.77 a |
| Quadrat | Mean Density | Variance | Mean Crowding | Clumping Index | Patchiness Index | Aggregation Index | Negative Binomial Distribution | Diffusion Coefficient | Distribution Pattern |
|---|---|---|---|---|---|---|---|---|---|
| 1 | 0.231 | 0.023 | −0.330 | −0.030 | −1.429 | −3.898 | −0.257 | 0.100 | uniform |
| 2 | 0.193 | 0.018 | −0.261 | −0.022 | −1.352 | −4.698 | −0.213 | 0.093 | uniform |
| 3 | 0.237 | 0.029 | −0.349 | −0.038 | −1.473 | −3.703 | −0.270 | 0.122 | uniform |
| Pesticides | 1 d After Treatment | 3 d After Treatment | 5 d After Treatment | 7 d After Treatment | ||||
|---|---|---|---|---|---|---|---|---|
| Decrease Rate | Control Efficacy | Decrease Rate | Control Efficacy | Decrease Rate | Control Efficacy | Decrease Rate | Control Efficacy | |
| 10% nitenpyram AS | 75.53 ± 1.31 c | 73.87 ± 1.40 c | 84.93 ± 1.46 c | 83.34 ± 1.62 cd | 89.26 ± 1.24 bc | 86.94 ± 1.51 bc | 96.82 ± 0.83 a | 95.74 ± 1.12 b |
| 4.5% beta-cypermethrin EC | 73.6 ± 1.77 c | 71.86 ± 1.86 c | 83.70 ± 2.04 c | 81.99 ± 2.25 d | 87.72 ± 1.50 c | 85.06 ± 1.83 c | 93.13 ± 0.94 b | 90.81 ± 1.26 c |
| 3.5% lambda-cyhalothrin·emamectin benzoate ME | 67.02 ± 1.66 d | 64.79 ± 1.77 d | 73.99 ± 1.99 e | 71.25 ± 2.20 f | 80.99 ± 1.36 d | 78.22 ± 2.27 de | 89.92 ± 1.41 bc | 87.40 ± 2.64 d |
| 40% phoxim EC | 90.98 ± 1.64 a | 90.37 ± 1.75 a | 100 ± 0.00 a | 100 ± 0.00 a | 100 ± 0.00 a | 100 ± 0.00 a | 100 ± 0.00 a | 100 ± 0.00 a |
| 2.5% lambda-cyhalothrin EW | 72.78 ± 1.10 c | 70.94 ± 1.18 c | 79.20 ± 1.39 d | 77.01 ± 1.54 e | 85.36 ± 1.36 c | 82.19 ± 1.64 cd | 92.45 ± 0.75 bc | 89.90 ± 1.00 c |
| 8000 IU/mg Bacillus thuringiensis WP | 48.90 ± 1.29 e | 45.44 ± 1.38 e | 54.92 ± 1.43 f | 50.17 ± 1.58 g | 59.60 ± 1.55 f | 50.85 ± 1.89 g | 71.97 ± 1.40 e | 62.50 ± 1.87 f |
| 1.8% abamectin EC | 85.56 ± 0.82 b | 84.59 ± 0.87 b | 94.88 ± 1.37 b | 94.34 ± 1.51 b | 97.62 ± 1.37 a | 97.47 ± 1.30 a | 1000.00 a | 100 ± 0.00 a |
| 50% thiamethoxam WDG | 66.17 ± 1.12 d | 62.88 ± 1.19 d | 73.53 ± 1.11 e | 70.75 ± 1.23 f | 80.87 ± 1.29 d | 76.73 ± 1.57 e | 89.61 ± 1.19 c | 86.10 ± 1.59 d |
| 150 g/L indoxacarb EC | 46.68 ± 1.53 e | 43.07 ± 1.63 e | 56.84 ± 1.45 f | 52.30 ± 1.61 g | 69.70 ± 1.32 e | 63.14 ± 1.60 f | 80.14 ± 1.71 d | 73.42 ± 2.29 e |
| 0.3% azadirachtin EC | 85.15 ± 1.80 b | 84.55 ± 1.60 b | 87.56 ± 1.55 c | 87.22 ± 1.26 c | 92.27 ± 0.89 b | 90.60 ± 1.09 b | 97.03 ± 0.88 a | 96.03 ± 1.17 b |
| CK | 6.34 | — | 9.52 | — | 17.80 | — | 25.27 | — |
| Pesticides | Dilution | Hyphal Diameter (cm) | Average Value | Inhibition Rate | ||
|---|---|---|---|---|---|---|
| 1 | 2 | 3 | ||||
| 40% phoxim EC | 1600 | 1.00 | 1.22 | 1.17 | 1.13 | 87.10% a |
| 4.5% beta-cypermethrin EC | 3200 | 6.05 | 6.12 | 5.90 | 6.02 | 31.29% bc |
| 2.5% lambda-cyhalothrin EW | 1200 | 6.10 | 5.87 | 4.00 | 5.32 | 39.24% b |
| 1.8% abamectin EC | 3200 | 6.72 | 6.54 | 6.67 | 6.64 | 24.24% c |
| CK | - | 8.90 | 8.57 | 8.84 | 8.77 | - |
| Sample Description and Number | Test Items | Test Results | Test Methods |
|---|---|---|---|
| J0074057F1 | beta-cypermethrin | not detected (detection limit 0.01) | GB 23200.113-2018 |
| J0088927F1 | lambda-cyhalothrin | not detected (detection limit 0.0005) | GB/T 20769-2008 |
| J0088927F1 | azadirachtin | not detected (detection limit 0.007) | NY/T 1379-2007 |
Disclaimer/Publisher’s Note: The statements, opinions and data contained in all publications are solely those of the individual author(s) and contributor(s) and not of MDPI and/or the editor(s). MDPI and/or the editor(s) disclaim responsibility for any injury to people or property resulting from any ideas, methods, instructions or products referred to in the content. |
© 2025 by the authors. Licensee MDPI, Basel, Switzerland. This article is an open access article distributed under the terms and conditions of the Creative Commons Attribution (CC BY) license (https://creativecommons.org/licenses/by/4.0/).
Share and Cite
Bai, X.; Wang, Y.; Wang, M.; Zhang, J.; Wu, L.; Wang, X.; Li, Y. Distribution of Oligaphorura ursi in Morchella Cultivation Soil, Screening of Pesticides, and Analysis of Their Effects on Mycelial Growth and Pesticide Residues. Horticulturae 2025, 11, 471. https://doi.org/10.3390/horticulturae11050471
Bai X, Wang Y, Wang M, Zhang J, Wu L, Wang X, Li Y. Distribution of Oligaphorura ursi in Morchella Cultivation Soil, Screening of Pesticides, and Analysis of Their Effects on Mycelial Growth and Pesticide Residues. Horticulturae. 2025; 11(5):471. https://doi.org/10.3390/horticulturae11050471
Chicago/Turabian StyleBai, Xueqian, Yicong Wang, Muhan Wang, Jiabei Zhang, Lingyue Wu, Xuecheng Wang, and Yiping Li. 2025. "Distribution of Oligaphorura ursi in Morchella Cultivation Soil, Screening of Pesticides, and Analysis of Their Effects on Mycelial Growth and Pesticide Residues" Horticulturae 11, no. 5: 471. https://doi.org/10.3390/horticulturae11050471
APA StyleBai, X., Wang, Y., Wang, M., Zhang, J., Wu, L., Wang, X., & Li, Y. (2025). Distribution of Oligaphorura ursi in Morchella Cultivation Soil, Screening of Pesticides, and Analysis of Their Effects on Mycelial Growth and Pesticide Residues. Horticulturae, 11(5), 471. https://doi.org/10.3390/horticulturae11050471





